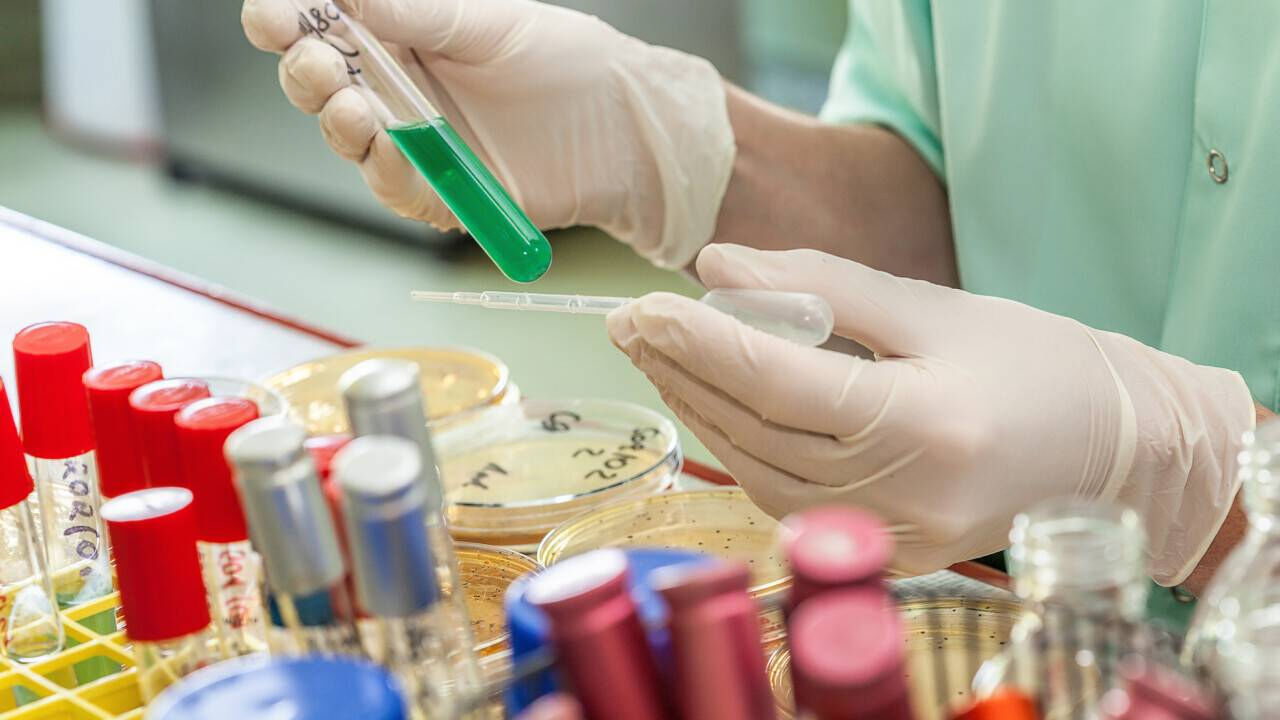
По шефскому велению

По шефскому велению
Очередной скандал назревает в полицейском министерстве
На сей раз речь идет не о добровольно-принудительных поборах в различные фонды при МВД, о которых наша газета уже неоднократно сообщала (см. “Вот это кадры!” и “Дань по приказу”, “Время” от 16.1 и 6.2.2025 г.). Дело в том, что всех сотрудников полиции - а их в стране около 125 тысяч - обязали срочно пройти наркоскрининг за свой счет. Соответствующее указание еще 16 января этого года было разослано по региональным департаментам полиции, а оттуда - по районным подразделениям.
Некоторые стражи правопорядка уже начали приносить в отделы кадровой и воспитательной работы справки из лаборатории с результатами наркотеста. Большинство попросили небольшую отсрочку: они пойдут сдавать анализы, когда получат зарплату.
Отдельные полицейские, знающие нормы законодательства, отказываются сдавать анализ на наркотики за свой счет. Их доводы сводятся к тому, что каждый год полицейские проходят профосмотр и в перечне врачей имеется нарколог. Но таких правдорубцев в системе МВД единицы. К слову, штатные наркологи работают в ведомственных поликлиниках и в санатории МВД “Казахстан” с госпиталем. Возникает вопрос: почему тогда полицейских вынуждают проходить наркотест платно и неизвестно где?
Информация об очередных поборах дошла до ветеранов МВД, и несколько инициативных групп уже написали жалобы, адресованные руководителям ведомства. Вскоре выяснилось: наркотест - это не очередная прихоть, а выполнение поручения администрации президента. Как оказалось, полицейские обязательно должны сдать тесты на наркотики исключительно за счет министерства. Но в МВД таких средств почему-то не оказалось.

Между тем в интернете немало предложений различных лабораторий по проведению анализов на наркотики. Например, популярная сеть лабораторной клиники тест на марихуану предлагает провести за 6410 тенге, на опиаты он стоит 6620. Другая не менее известная клиника за 6750 тенге предлагает тест-панель на определение сразу трех видов наркотиков - опиаты, марихуана/гашиш, амфетамины. В общем, в сети немало предложений провести такие анализы.
В распоряжении редакции оказалась копия одного письма на имя руководства МВД, где автор говорит о цене в 9 тысяч тенге, которые необходимо заплатить за справку. Видимо, все-таки последовало какое-то устное указание по ведомственным чатам. Кроме того, речь идет и о том, что наркозависимым полицейским вообще не должно быть места в правоохранительных органах. Здесь автор прав: в последние годы сотрудники МВД стали совершать дорожные аварии после употребления наркотиков. Начали сбывать зелье и порой приходить на службу под воздействием наркотиков. И такие случаи нередки.
По самым скромным подсчетам, если все полицейские Казахстана поголовно пройдут обследование (а это неизбежно), то касса какой-нибудь частной лаборатории пополнится на 1 125 000 000 тенге! Несколько знакомых сотрудников полиции в доверительном разговоре признались, что эта правильная в принципе инициатива может превратиться в очередную кормушку для какого-нибудь высокопоставленного руководителя МВД. Правда, открыто говорить об этом боятся.

Но ветераны системы оказались более смелыми и открытыми. Мы связались с автором одного из писем в полицейский главк подполковником в запасе Сержаном АРШАБЕКОВЫМ.
- Тесты на наркотики нужны, тем более что среди личного состава начали выявлять наркозависимых, чего в наше время даже в кошмарном сне не привиделось бы, - говорит отставник. - Но проходить тесты за счет самих сотрудников как минимум незаконно. Раз МВД обязало пройти, значит, должно и оплатить услуги лаборатории. Мы не знаем, где именно должны проходить наркотесты полицейские. Возможно, это частная клиника, а не госучреждение.
К примеру, недавно Высшая аудиторская палата установила, что из бюджета незаконно выделили около 16 миллиардов тенге двум медицинским организациям Астаны, которые вообще не имели лицензий и права оказывать медуслуги населению. Где гарантия, что полицейских не отправили в такую же клинику? Два года идет борьба за восстановление ведомственного санатория “Казахстан”, который уничтожили некоторые бывшие руководители здравницы. Сейчас для восстановления нужно 5-6 миллиардов тенге, но в правительстве не могут найти их, хотя в три раза больше выделили двум абсолютно левым медорганизациям.
- Глава государства дал конкретное поручение правительству восстановить работу нашего госпиталя. На эту тему с нами, ветеранами, несколько раз встречалась теперь бывший вице-премьер Тамара ДУЙСЕНОВА. Я был у нее на личном приеме, она обещала решить вопрос восстановления, говорила, что держит проблему на контроле. Этого ждет коллектив из более чем 300 профессиональных медработников. Ждут ветераны и действующие сотрудники органов внутренних дел и Нацгвардии. Госпиталь - это важный объект социальной инфраструктуры, а не торговый дом, - считает наш собеседник.
Кто знает, работай санаторий с госпиталем сегодня, может, полицейским не пришлось бы платить по 9 тысяч тенге из зарплаты за наркоскрининг.
Тохнияз КУЧУКОВ, фото Владимира ЗАИКИНА и с сайтов qaz-media.kz и currenttime.tv, Алматы


 Тохнияз КУЧУКОВ
Тохнияз КУЧУКОВ





